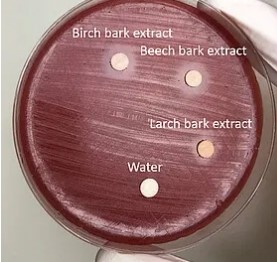

Since June 2024, the podcast "Health Talk" has been featuring current health topics from research and society in conversations with researchers and students from the Department of Health Sciences, as well as other experts and affected individuals. A new episode is now online.

In the latest episode of OxiWoundWood: How tree bark extracts support the healing of diseases, Anja Schuster and Sissy Häsler Gunnarsdottir, researchers in the Biomedical Sciences degree programme, explain how bioactive extracts from the bark of native tree species could contribute to the healing of skin diseases such as acne, neurodermatitis or epidermolysis bullosa in the future. The effect of bark extracts against specific bacteria has already been repeatedly demonstrated in chemical and biological assays. Phytochemical substances have been used for centuries to improve diseases in the course of naturopathy and are used in the field of drug production. Not least because of the growing resistance to antibiotics, research into plant-based active ingredients has gathered pace. The two researchers therefore also take a closer look at whether the active ingredients from trees might even have the potential to be used as “natural antibiotics”.
Listen to this exciting topic now and spread the word!